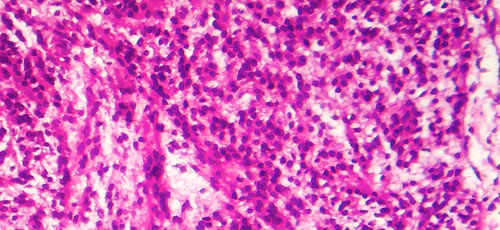
成纤维细胞

成纤维细胞
专注于皮肤的再生医学
什么是成纤维细胞(皮肤结构细胞)?
成纤维细胞存在于人体各处的结缔组织中,包括皮肤的真皮层。它们在维持皮肤结构和促进组织再生方面发挥着重要作用。
成纤维细胞能够生成皮肤的重要结构成分,如胶原蛋白、弹性蛋白和透明质酸,这些物质有助于维持皮肤的弹性、保湿能力以及组织支撑结构。
三大主要功能
1. 胶原蛋白生成
胶原蛋白是维持皮肤结构完整性最重要的蛋白质。
成纤维细胞在皮肤真皮层中生成胶原蛋白,有助于维持皮肤的紧致度与弹性。
2. 弹性蛋白生成
弹性蛋白是一种使皮肤能够伸展并恢复原状的蛋白质,有助于保持皮肤的柔韧性和弹性。
3. 透明质酸生成
透明质酸是一种维持皮肤水分的重要物质,能够让皮肤保持水润、光滑与健康。
随着年龄增长或受到环境因素影响,成纤维细胞的活性会逐渐下降。这种变化可能导致胶原蛋白生成减少以及皮肤再生能力下降,从而出现皱纹增多、皮肤弹性降低以及皮肤松弛等衰老现象。
此外,成纤维细胞在组织修复过程中也发挥着重要作用。当组织受到损伤或发生炎症时,成纤维细胞会参与新组织的形成,并帮助皮肤完成自然的再生过程。
成纤维细胞与皮肤老化
在皮肤老化过程中,最显著的变化之一是成纤维细胞功能的逐渐下降。
随着年龄的增长,成纤维细胞的活性会逐渐减弱,胶原蛋白的生成也随之减少,皮肤的再生能力逐步降低。这些变化可能会导致常见的皮肤老化现象,例如:
- 皱纹增加
- 皮肤弹性下降
- 皮肤组织密度降低
- 皮肤松弛下垂
因此,成纤维细胞的活性被认为是维持皮肤健康以及影响皮肤老化过程的重要因素。
成纤维细胞与干细胞的区别
成纤维细胞和干细胞都与人体组织密切相关,但在功能和作用方面存在明显差异。
| 细胞类型 | 特征 |
|---|---|
| 成纤维细胞 | 维持皮肤结构并支持组织形成 |
| 干细胞 | 具有分化为多种细胞类型的能力 |
干细胞具有分化为多种不同细胞类型的能力,而成纤维细胞则是专门负责维持和支持皮肤组织结构的功能性细胞。
(了解更多关于干细胞)
专注于皮肤的再生医学
成纤维细胞在皮肤再生中的治疗应用

人体皮肤中含有多种重要成分,例如胶原蛋白、透明质酸和弹性蛋白,这些物质是维持皮肤弹性、保湿能力和韧性的基础。这些成分由皮肤细胞生成,但这些细胞会因压力、紫外线照射等因素而受到损伤,并随着年龄的增长逐渐失去功能,这些都是导致皱纹和皮肤松弛的重要原因。
成纤维细胞移植治疗通过改善皮肤组织状态,帮助肌肤恢复原有的年轻与活力,使皮肤看起来更加紧致和健康。
使用患者自身皮肤细胞进行移植,以改善皱纹、皮肤松弛、提升弹性并恢复年轻光泽。
成纤维细胞治疗的作用机制
该治疗技术是先采集成纤维细胞,在专业培养设施中进行培养和扩增后,再将其移植到因年龄增长而出现问题的皮肤部位。通过这种方式,治疗旨在从皮肤内部改善因衰老产生的深层皱纹、皮肤松弛以及皮肤沟纹等问题。
1. 刚刚注入后

2.两星期至一个月后

3.六个月至一年之后


向我们的团队医生询问您的健康状况。
使用部位

成纤维细胞移植效果
在皮肤上植入成纤维细胞的治疗方法是可以让各个皮肤表层重新绽放活力。
皱纹
下垂
恢复弹力
光泽
美白
祛斑
活力
保湿
这种治疗有哪些优势?
成纤维细胞治疗功能
1. 利用自体细胞改善根本性的皮肤功能
2. 通过定期治疗起到延缓、再生老化的功效。
3. 可以在短时间内进行治疗
4. 日本保健福利部门认证
5. 专门医疗团队的特殊治疗
成纤维细胞治疗过程




我们实验室拥有很多经验,我们可以将细胞数培养为10,000倍之多。在此实验室里,在严格的标准下,细胞会被培养4~5周。



